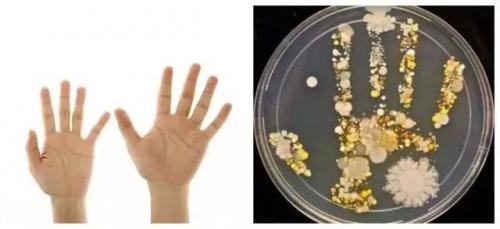
护手美肤又除菌,这才是洗手液的最高配置!

据美国科罗拉多大学博尔德分校的一个研究小组发现,每个人每只手上大约会有 150 种细菌。
另有研究表示,一双未洗过的手上最多约有 80 万个细菌!

近期一位美国做的一个手部细菌的实验,在微博上爆炸性传开,让很多人对洗手的问题产生了极大重视 ~
例如让孩子摸了自家的宠物狗,再去外面玩了一小会儿,回来后把手按在培养皿上。

培养一周后,便有了下面这张五彩斑斓的 " 细菌手印图 "。
橙色和黄色的斑点可能是酵母,右下方的大白圈可能是芽孢杆菌,小白点可能是葡萄球菌…(列出的只是冰山一角,手上细菌的种类数不胜数 ~~~)
看完只想赶紧去趟洗手间。

原来我们手上竟然有那么多细菌,所以为了自己和家人的健康,是时候用上一款高品质的洗手液开启精致生活了 ~
很多人会喜欢用洗手液或者香皂之类的来洗手,不管是洗手液或者香皂都是偏碱性的,所以才会有较强的消毒和杀菌的效果,但是人的皮肤长期接触这些物质,是会变粗糙的,所以要减少这些碱性制剂的使用,推荐一款很好用的洗手液。

瑰珀翠园艺大师温和洗手液
手部的泡泡浴,PH值均衡,清洁、滋养三效合一
淡雅草本清香,洁净怡人
瑰珀翠,英国护理品牌,有着四十多年的历史,在英国乃至全球各地畅销多年,他们家是做肥皂起家的,现在已经发展成为享誉国际的一线护理品牌,在全球超过三百家产品。她们家的产品是甄选世界各地天然草本调制而成,最大的特点是都是植物成分和香氛精油的完美糅合,强力吸水锁水,可迅速滋润干燥的手部肌肤,而且对气味的调制也特别好,还有产品颜值也非常高,特别适合精致香香的小仙女哦!最出名的产品是很多不同的气味类型的护手霜,磨砂膏,身体乳,洗手液等一系列产品。

每天下班回家做饭,放空心灵,享受生活,可以说是一种大大提升生活质量的方式了。

但经常洗碗做饭手部会被洗洁精的残留物质危害,久而久之手会越来越越干燥,手部肌肤也越来越暗沉、无光。
所以一个好的洗手液和好的护手霜真的很重要!

除了娇美的容颜、华贵的服饰,一双纤纤玉手的魅力更是让人无法抗拒。
都说手是女人的第二张脸,脸部肌肤保养好了,一双手却暗黄枯槁,这样的反差可不是我们精致小仙女该有的。
手也只有精心护养才能持久白嫩哦~
现在大家也不用找海外代购或者担心淘宝上假货横飞了,现在瑰珀翠在天猫国际上开了一个海外旗舰店,方便中国消费者。